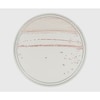

2商品
| 商品ラインアップ |
メーカー品番
|
数量
|
販売価格
|
カート |
|---|---|---|---|---|
|
|
252794
|
1個(20枚)
|
¥5,988
(税込)
|
¥5,988 (税込) |
|
|
252950
|
1個(100枚)
|
¥28,644
(税込)
|
¥28,644 (税込) |
共通の商品仕様 (各商品の仕様は、商品詳細ページでご確認ください)
各商品の仕様は、商品詳細ページでご確認ください
|
| 注意事項 |
※この商品は貯蔵または配送の際に冷蔵が必要な商品です。 ※【返品に関するご注意】この商品は直送品のため、お客様のご都合による返品はお受けできません。 |
|---|